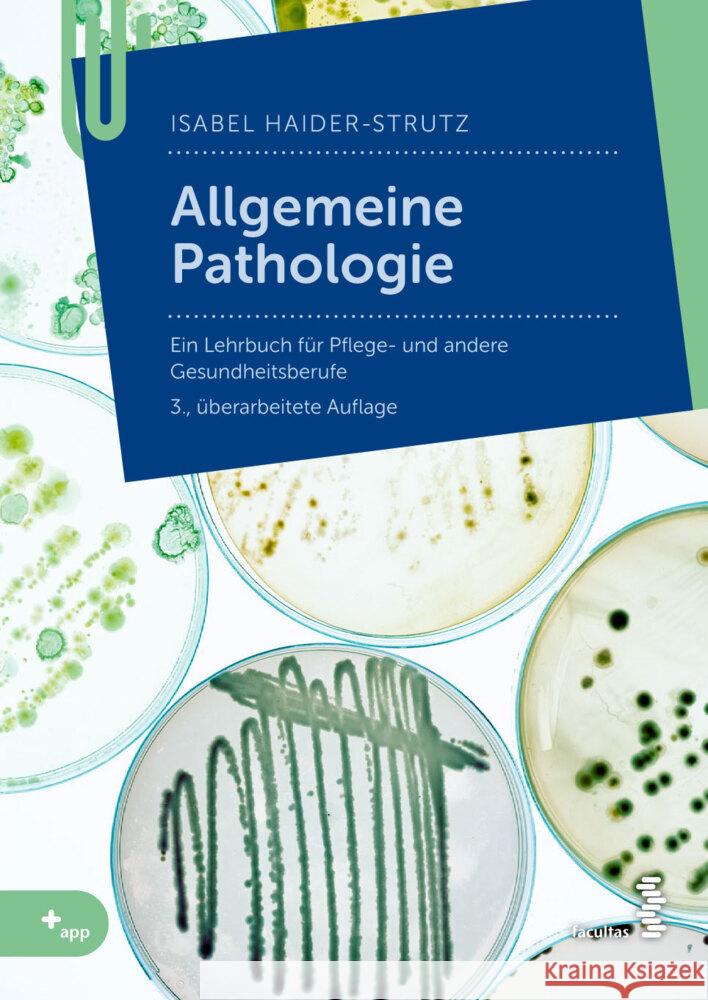
Allgemeine Pathologie Haider-Strutz, Isabel 9783708921709 Facultas - książka

Allgemeine Pathologie » książka
topmenu
Allgemeine Pathologie
ISBN-13: 9783708921709 / Niemiecki / Miękka / 232 str.
Dieses Buch bietet eine fundierte Auseinandersetzung mit dem Fach der Allgemeinen Pathologie. Sie erfahren alles über die Ursachen, Verläufe und Folgen von Krankheiten sowie über grundlegende medizinisch-biologische Vorgänge (Tumorbildung, Entzündungen, Zell- und Gewebsschäden, Störungen des Kreislaufs, Wundheilung, Funktion des Immunsystems usw.). Mit vielen neuen, farbigen Abbildungen!Für Auszubildende, Studierende und Lehrende der Gesundheits- und Krankenpflegeausbildungen sowie weitere Gesundheitsberufe.